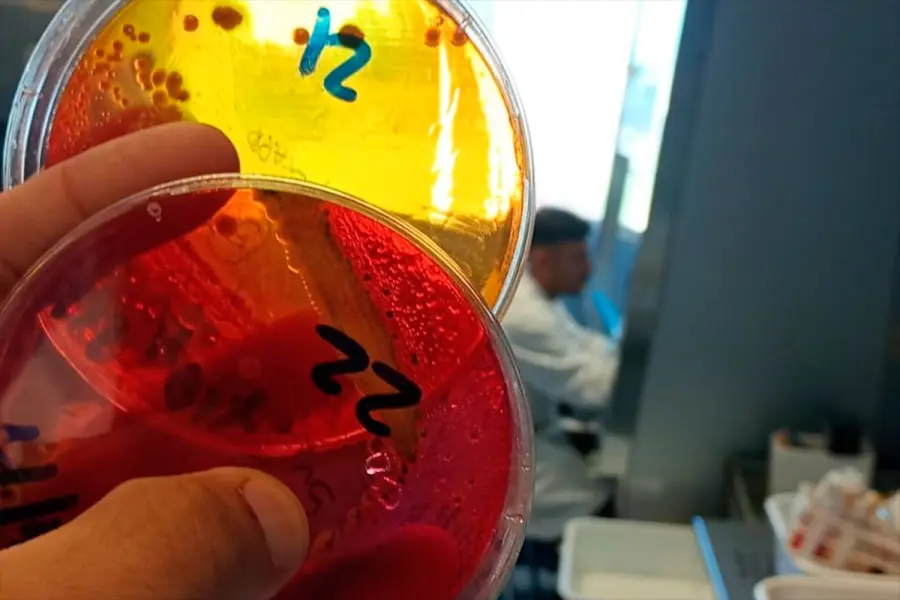

La Unidad de Investigación Avícola del INTA Concepción del Uruguay se integró a la Red Nacional de Laboratorios del SENASA, fortaleciendo el control sanitario y la calidad de los análisis.
La incorporación del laboratorio del INTA Concepción del Uruguay a la Red Nacional de Laboratorios del SENASA marcó un avance clave para el sistema sanitario y productivo, al fortalecer la calidad y confiabilidad de los análisis vinculados al sector avícola.
Se trata de la Unidad de Investigación Avícola (UIA) de la Estación Experimental Agropecuaria, que logró su integración tras cumplir con exigentes estándares vinculados a sistemas de calidad, buenas prácticas de laboratorio y competencias técnicas del personal.
Estas condiciones se encuentran alineadas a normativas nacionales e internacionales, lo que garantiza la validez y reconocimiento de los resultados obtenidos.

Habilitación para análisis de Salmonella
En esta primera etapa, el laboratorio quedó habilitado para el análisis de Salmonella spp., uno de los principales patógenos de interés sanitario en la producción avícola. Este avance permite brindar respuestas analíticas rápidas y con respaldo oficial del SENASA, lo que resulta fundamental para el sector productivo de la región.
Además, se informó que el equipo ya trabaja en la incorporación de nuevos alcances, con el objetivo de ampliar la capacidad operativa del laboratorio.
Un proceso de mejora sostenido
El ingreso a la Red Nacional de Laboratorios fue el resultado de un proceso de más de un año y medio de trabajo continuo. Durante ese período se adecuaron procedimientos, se fortalecieron capacidades técnicas y se consolidó un sistema de calidad robusto.
Este esfuerzo permitió alcanzar los estándares requeridos para formar parte de una red que garantiza uniformidad en los análisis a nivel nacional.
Impacto en el sector productivo
La integración a la RedLab no solo valida técnicamente los resultados generados, sino que también posiciona al laboratorio como un actor estratégico para el sector avícola.
El acceso a análisis con reconocimiento oficial permite mejorar la toma de decisiones sanitarias y productivas, reduciendo tiempos y aumentando la confiabilidad de los diagnósticos. Asimismo, la articulación con otros laboratorios del país contribuye a fortalecer el control de enfermedades y agilizar la gestión de muestras.
Proyección y crecimiento
Desde el equipo técnico destacaron que el objetivo es continuar ampliando las capacidades del laboratorio mediante la validación de nuevos rubros de análisis. Esto permitirá ofrecer más servicios al sector avícola y acompañar las demandas crecientes con estándares de calidad cada vez más exigentes.
La incorporación a la Red Nacional de Laboratorios del SENASA refuerza así el compromiso del INTA con la excelencia técnica y su rol en el entramado sanitario-productivo del país.








